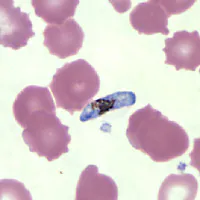
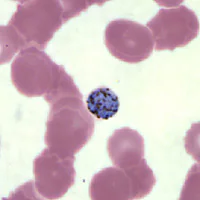
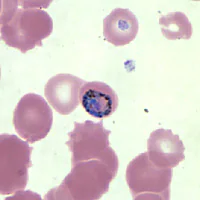
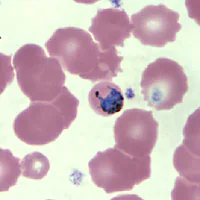
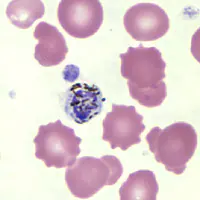
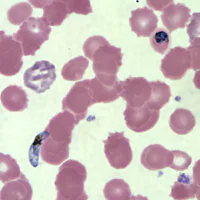

Case #147 – January, 2005
A 75-year-old man had gastrointestinal bleeding while in Nigeria and received 8 units of whole blood that was reportedly imported from India. After his return to the United States two months later, he experienced fever (101º) and chills. Blood smears were submitted to a laboratory; one Plasmodium species was identified but assistance was requested for identification of a possible second species. Figures A-F were observed on a Wright’s-Giemsa stained thin smear. What is your diagnosis and species determination? Based on what criteria?
Figure A
Figure B
Figure C
Figure D
Figure E
Figure F
Images presented in the DPDx case studies are from specimens submitted for diagnosis or archiving. On rare occasions, clinical histories given may be partly fictitious.
DPDx is an educational resource designed for health professionals and laboratory scientists. For an overview including prevention, control, and treatment visit www.cdc.gov/parasites/.
